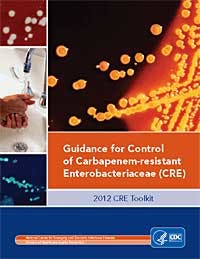
Toolkit Cre Fo Toolkit Cre Fo

A killer among us: deadly CRE bacteria
Superbugs that have killed seven at the National Institutes of Health (NIH) have struck at hospitals across the USA. The scope of the problem remains elusive, even to the Centers for Disease Control (CDC), and there are no drugs on the horizon to stop killer bacteria. For more on deadly superbugs, read this USA Today article at superbugs. The superbug that hit University of Virginia Medical Center (UVA) four years ago, and remains a threat today, belongs to a once-obscure family of drug-resistant bacteria that has haunted U.S. hospitals and nursing homes for over a decade. Now, it's attacking in hundreds of those institutions, and it's a fight the medical community is not well positioned to win.
The bacteria, known as Carbapenem-Resistant Enterobacteriaceae (CRE), are named for their ability to fight off carbapenem antibiotics, the last line of defense in the medical toolbox. And so far, they've emerged almost exclusively in health care facilities, attacking the weakest of patients. Several resistance mechanisms are responsible for highly antibiotic-resistant Gram-negative bacilli, such as CRE. Klebsiella pneumoniae carbapenemase (KPC) is currently the most common resistance mechanism causing CRE in the United States.(1) In light of the clinical and infection control challenges posed by CRE and advances in the ability to detect these pathogens, CDC and HICPAC have developed new guidance for CRE infection prevention and control in an effort to limit the further emergence of these organisms. These recommendations are based on strategies outlined in the 2006 Healthcare Infection Control Practices Advisory Committee (HICPAC) guidelines for management of multidrug-resistant organisms in health-care settings (2). The Healthcare Infection Control Practices Advisory Committee (HICPAC) is a federal advisory committee assembled to provide advice and guidance to the Centers for Disease Control and Prevention (CDC) and the Secretary of the Department of Health and Human Services (HHS) regarding the practice of infection control and strategies for surveillance, prevention, and control of healthcare-associated infections, antimicrobial resistance and related events in United States healthcare settings.(3) CDC has identified Enterobacteriaceae isolates carrying a newly described resistance mechanism, New Delhi metallo-beta-lactamase (NDM-1). Carriage of these organisms is closely linked to recent receipt of medical care in India or Pakistan.(4) Clinicians are advised to call the CDC if treating a patient in which a CRE is detected and who has received medical care in India or Pakistan within the past 6 months. And last but not least, in July 2010, the CDC was notified of a patient with a carbapenem-resistant Klebsiella pneumoniae strain that produced a Verona integron-encoded metallo-beta-lactamase (VIM) carbapenemase.(5)
“Hand Washing is the single most important means of preventing the spread of infection” Hand hygiene is critical in all health care settings, such as dental offices and clinics, but especially for those working in long-term care facilities such as hospitals and nursing homes.(6) In the 2012 CRE Toolkit - Guidance for Control of Carbapenem-resistant Enterobacteriaceae (CRE), unless otherwise specified, healthcare facilities refer to all acute care hospitals and any long-term care facility that cares for patients who remain overnight and regularly require medical or nursing care (e.g., maintenance of indwelling devices, intravenous injections, wound care, etc.). This would include all long-term acute care hospitals and skilled nursing homes (including certain rehabilitation facilities), but would generally exclude assisted living facilities and nursing homes that do not provide more than basic medical care. In addition, this toolkit is not intended for use in ambulatory care facilities.
The most common mode of transmission of pathogens is via hands!(7) Substantial evidence that hand hygiene reduces the incidence of infections.(6) Hand washing and alcohol-based handrubs are recommended. Natural nail tips should be kept to ¼ inch in length, and artificial nails should not be worn when having direct contact with high-risk patients.
The bacteria's ability to overwhelm even the most potent antibiotics has stirred up fears of illnesses that are not able to be stopped. Death rates among patients with CRE infections can be about 40%, far worse than other, better-known health care infections such as MRSA or C-Diff, which have plagued hospitals and nursing homes for decades. And there are growing concerns that CRE could make its way beyond health facilities and into the general community. The big fear is that the genes may start to convey resistance to more common strains of the bacteria, turning routine illnesses, such as urinary tract infections, into untreatable nightmares. A worst-case scenario that has been proposed…resistance could move to bacteria outside of health care, so people could pick it up in the community through something as simple as a handshake. Let’s do our small part in keeping this threat to a minimum!
(8)References 1. Guidance for Control of Infections with Carbapenem-Resistant or Carbapenemase-Producing Enterobacteriaceae in Acute Care Facilities. CDC and HICPAC Recommendations. CDC; MMWR March 20, 2010 / 58(10);256-260. 2. http://www.cdc.gov/mmwr/preview/mmwrhtml/mm5810a4.htm?s_cid=mm5810a4_e#box. 3. http://www.cdc.gov/hicpac/. 4. Detection of Enterobacteriaceae Isolates Carrying Metallo-Beta-Lactamase --- United States, 2010. CDC; MMWR June 25, 2010 / 59(24);750. 5. Detection of a Verona Integron-Encoded Metallo-Beta-Lactamase (VIM) in Klebsiella pneumoniae - United States, 2010. CDC; MMWR September 24, 2010 / 59(37);1212. 6. MMWR Recommendations and Reports. Guideline for Hand Hygiene in Health-Care Settings. October 25, 2002 / 51(RR16);1-44. 7. CDC. Hand Hygiene in Healthcare Settings: CDC Core Slide Set. 8. Eisler, P. Deadly 'superbugs' invade U.S. health care facilities. USA Today. November 29, 2012. http://www.usatoday.com/story/news/nation/2012/11/29/bacteria-deadly-hospital-infection/1727667/.Additional Reading 2012 CRE Toolkit - Guidance for Control of Carbapenem-resistant Enterobacteriaceae (CRE). http://www.cdc.gov/hai/pdfs/cre/CRE-guidance-508.pdf.